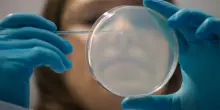
Cellule staminali contro il Parkinson, l&rsquo;annuncio in Giappone e a che punto &egrave; la ricerca

s
Tutte le prime pagine di oggi su Giornalone.it

Cellule staminali mascherate per sfuggire al rischio di rigetto
Oggi 09-03-26, 12:22
Testate nei topi, aprono a cellule universali per tutti i pazienti
CONTINUA A LEGGERE

4

0

0